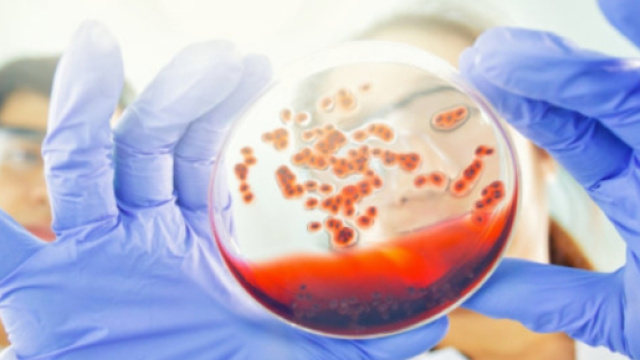
Il secondo caso di guarigione da HIV

Londra, una buona notizia arriva dal campo medico: un uomo malato di HIV, dopo aver ricevuto un trapianto di midollo osseo da parte di un donatore resistente all'HIV, è riuscito a neutralizzare il virus. Si tratta del secondo caso al mondo. Dopo tre anni dal trapianto, i vari test condotti dai medici che seguono l'uomo, non mostrano ancora nessuna traccia dell'Aids. Il paziente in questione ha preferito restare anonimo ma ha lasciato che il suo caso venisse divulgato al mondo, lasciando aperta la porta della speranza per tutti coloro colpiti dell'infezione.
Le dichiarazioni dei medici
Ravindra Gupta, il medico che ha guidato il team in questa impresa al momento vittoriosa, ha dichiarato alla stampa che il virus non si è ripresentato nel paziente in questione. Ha sottolineato tuttavia che è ancora presto per parlare di una effettiva guarigione. ma si tratta comunque di una "remissione a lungo termine".. Si tratta del secondo caso al mondo in cui si riesce a liberare l'organismo da questo pericoloso virus. Nel 2007 in Germania, a Berlino, Timothy Brown, è passato alle cronache come il primo uomo a sconfiggere il suo virus HIV. A 12 anni dal suo intervento Brown continua a risultare negativo ai test infettivi.
I dati
Circa 37 milioni di persone in tutto il mondo sono attualmente infette dall'HIV e la pandemia dell'AIDS ha ucciso circa 35 milioni di persone in tutto il mondo dall'inizio degli anni '80.
La ricerca scientifica sul complesso virus ha portato negli ultimi anni allo sviluppo di combinazioni di di nuovi farmaci che possono tenerlo a bada nella maggior parte dei pazienti. Ora la strada intrapresa con il trapianto di midollo osseo sembra essere una strategia vincente. Il trapianto, nel caso londinese, ha cambiato il sistema immunitario del paziente, dandogli la mutazione del donatore e la resistenza all'HIV. I trapianti di cellule staminali sono in genere procedure severe che iniziano con la radioterapia o la chemioterapia per danneggiare il sistema immunitario esistente del corpo e fare spazio a uno nuovo. Ci sono anche complicazioni. Brown, per esempio, dovette sottoporsi a un secondo trapianto di cellule staminali quando la sua leucemia tornò.
Sebbene i trapianti di cellule staminali non siano una terapia praticabile per la maggior parte delle persone con HIV, ciò non diminuisce l'eccitazione per il nuovo caso dalla comunità di ricerca, che si è interessata ad usare la terapia genica per disabilitare il gene CCR5 usando altre tecnologie, tra cui la tecnologia di modifica dei geni CRISPR.